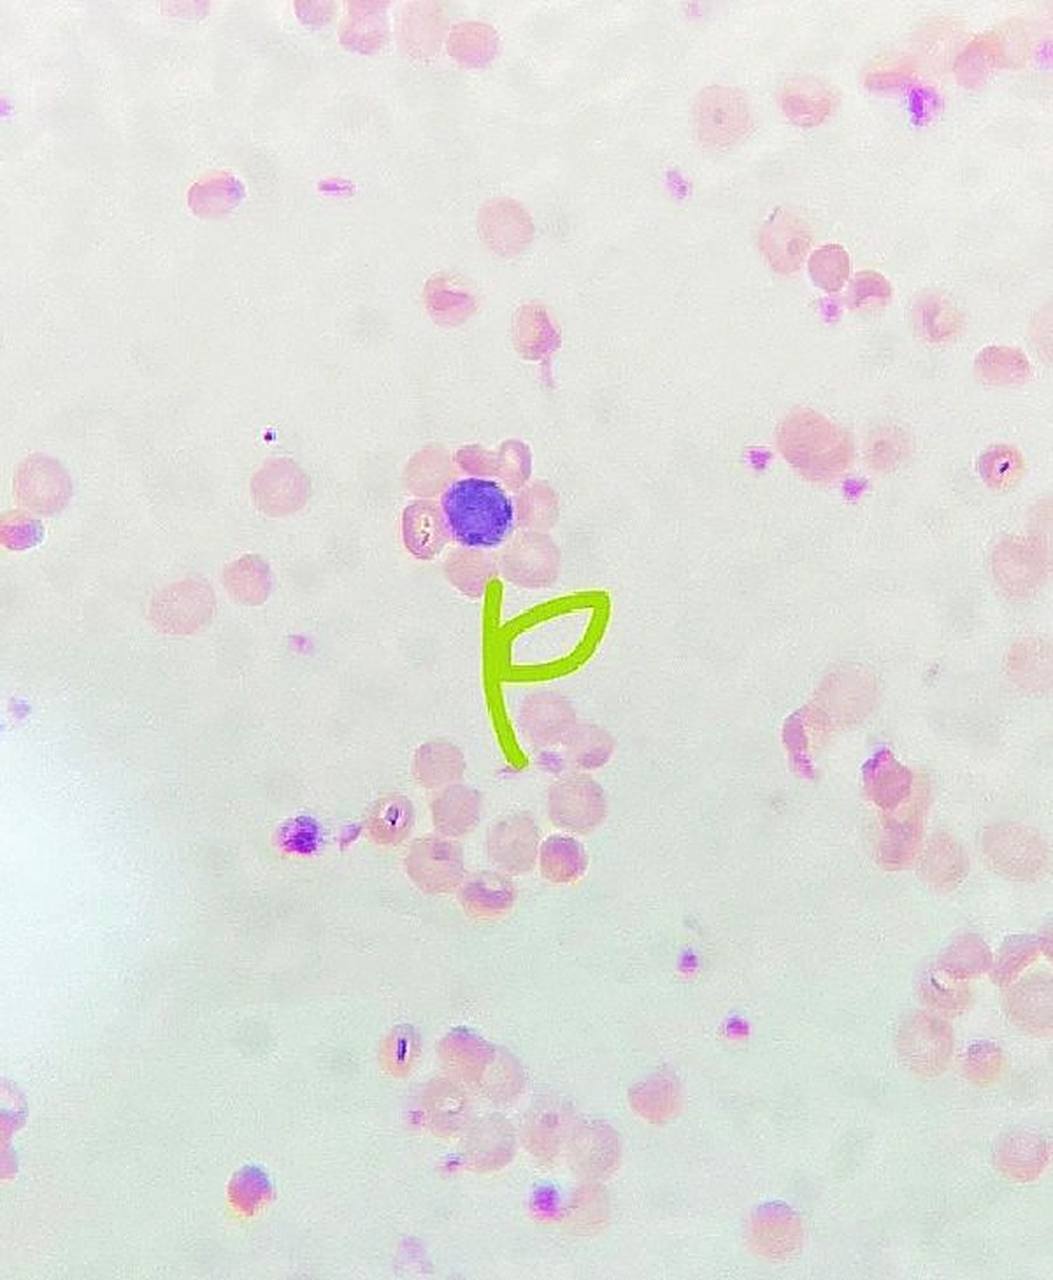
医学实验,e-玫瑰花环形成实验  e-玫瑰花环实验 有幸遇见一朵盛开的花

e花环实验结果绘图

病原实验报告第六弹 e花环 淋巴细胞的正常 过渡型和转化型 小吞噬
图片尺寸2095x1280
e花环实验
图片尺寸268x263医学实验 制作切片观察,活性e-花环
图片尺寸1080x1439
组胚红蓝铅笔手绘图知识点总结按需自取
图片尺寸720x960
医学实验,e-玫瑰花环形成实验 e-玫瑰花环实验 有幸遇见一朵盛开的花
图片尺寸1053x1280
e花环实验报告
图片尺寸482x486
e-花环
图片尺寸720x960
实验三e花环ppt
图片尺寸1080x810
e花环实验报告.doc
图片尺寸792x1120
e花环实验报告
图片尺寸482x481
e花环实验报告
图片尺寸920x1303
组胚实验红蓝铅笔绘图 - 知乎
图片尺寸4032x3024
e花环实验报告
图片尺寸920x1302
免疫学实验—e花环实验
图片尺寸4000x3000
e玫瑰花环细胞手绘图
图片尺寸422x273
e玫瑰花环
图片尺寸545x409
免疫学实验—e花环实验
图片尺寸1536x2048
实验一免疫学实验 一,免疫细胞检测: 1,淋巴细胞转化试验2,e花环形成
图片尺寸496x702
lecture4-e花环试验幻灯片.ppt
图片尺寸1152x864
实验
图片尺寸224x299
猜你喜欢:e花环e花环红蓝铅笔手绘图E花环实验e花环实验红蓝铅笔图e花环细胞手绘图e花环实验的手绘图e花环形成实验手绘图e玫瑰花环实验手绘图e花环实验e花环绘图e玫瑰花环实验报告e花环实验报告e花环手绘图e玫瑰花环试验免疫e花环示教画图e玫瑰花环手绘图e花环镜下图解剖绘图大赛手绘图e花环显微镜图片e花环图e玫瑰花环显微镜图片花环绘画e玫瑰花环红蓝铅笔图e花环红蓝铅笔e花环显微镜机械制图入门绘图花环图案花环手绘绘图制作淋巴小结红蓝铅笔绘图镂空地砖潘虹简介少年纪事谷明陈灵aida64背景图b超数值对照表正常值Q版运动人物决心鱼战斗曲简谱cos平方x图像2080super魔龙cfop公式高清图图解游戏图片1920江阴美程酒店